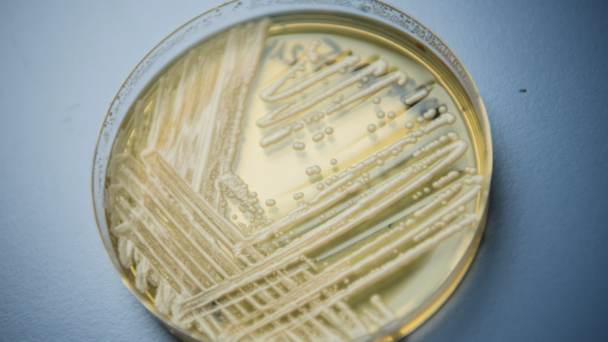

El mortal hongo ‘Candida auris’ se está extendiendo rápidamente en Estados Unidos, revela una investigación recientemente publicada en la revista American Journal of Infection Control.
Según los resultados del estudio, se identificaron 327 cultivos clínicos pertenecientes a 231 pacientes únicos. Los científicos descubrieron que el número de cultivos clínicos aumentó cada año, de 5 en 2019 a 29 en 2020, a 71 en 2021, a 107 en 2022 y, finalmente, a 115 en 2023. Los hemocultivos se presentaron como la fuente de infección más común.
Desde 2023, el ‘Candida auris’ está catalogado por los Centros para el Control y la Prevención de Enfermedades de EE.UU. (CDC, por sus siglas en inglés) como una «amenaza urgente de resistencia a los antimicrobianos», debido a su capacidad para resistir múltiples medicamentos antifúngicos, su facilidad de propagación en entornos de atención médica y su potencial para causar infecciones graves con altas tasas de mortalidad.
En ese mismo informe, un CDC detalló que, en general, el hongo no representa una amenaza para personas sanas. En cambio, los pacientes que se encuentran gravemente enfermos, que utilizan dispositivos médicos invasivos o que tienen estancias prolongadas o frecuentes en hospitales y otras instalaciones de salud son los más vulnerables a contraerlo.
Asimismo, hace poco se ha reportado un aumento exponencial en el estado de Georgia. De acuerdo con Joanna Wagner, del Departamento de Salud Pública local, a finales de febrero de este año se habían registrado más de 1.300 casos en la jurisdicción estatal.
Fuente: RT